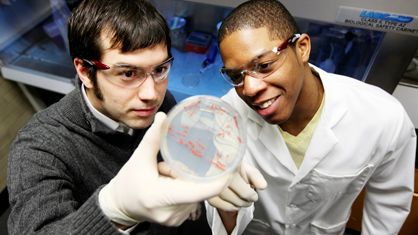
engage1

CSB-Wide Opportunities
CSB-Wide Opportunities
Excel in research, dialogue, and ethical considerations within synthetic biology
In addition to our state-of-the-art curriculum, our CSB-wide educational opportunities provide a collaborative environment for diverse researchers and enthusiasts to engage in interdisciplinary exploration of synthetic biology. Through workshops and conversations, we foster a vibrant discussion research and ethics.